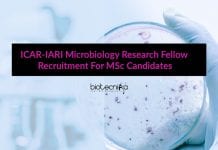
ICAR-IARI Microbiology Research Fellow Recruitment For MSc Candidates ICAR-IARI Microbiology Research Fellow

Life Sciences JRF Job In Salmonella Project at IISER Mohali
Life Sciences JRF Job In Salmonella Project at IISER Mohali
Life Sciences JRF Job In Salmonella Project at IISER Mohali. MSc Life Sciences junior research...
NCBS PhD Biology Scientific Officer Recruitment With Rs. 67,700 pm Pay
NCBS PhD Biology Scientific Officer Recruitment With Rs. 67,700 pm Pay
NCBS PhD Biology Scientific Officer Recruitment With Rs. 67,700 pm Pay. NCBS Jobs 2022....
CSIR-IGIB Project Vacancies For Life Sciences With Up To Rs. 78,000 pm Pay
IGIB Project Vacancies 2022 With Up to Rs. 78,000 pm Pay
IGIB Project Vacancies 2022 With Up to Rs. 78,000 pm Pay. CSIR-IGIB Project Recruitment...
Britannia Industries Limited QA Officer Job For Food Technology
Britannia Industries QA Job For Food Technology, Apply Online
Britannia Industries QA Job For Food Technology, Apply Online. Britannia Industries Limited Quality Assurance Jobs. QA...
SERB-Core Research Grant 2022 (Extramural Research Funding)
SERB-Core Research Grant 2022 (Extramural Research Funding)
The official notification for the SERB-Core Research Grant 2022 (Extramural Research Funding) has been announced. Indian nationals are...
DBT-NIAB PhD Admission Program RSP-I 2022, Apply Online
NIAB PhD Admission 2022 - RSP-I 2022, Apply Online
NIAB PhD Admission 2022 - RSP-I 2022, Apply Online. DBT-National Institute of Animal Biotechnology (NIAB) RSP-I...
Biotecnika Times Newsletter 05.04.2022 TIFR Recruitment, IISER Summer Internship, Bose
Biotecnika Times - TIFR Recruitment, IISER Summer Internship, Bose
CUET UG 2022 Online Application Form Update – Check Latest CUET UG 2022 Information
CUET UG 2022...
Want To Make A Career in Bioinformatics? Where & How to Start? Bioinformatics Questions...
Bioinformatics Career in India - Where & How to start with Bioinformatics
Want to start a career in bioinformatics? A million-dollar question is posed in...
AIIMS New Delhi Project Associate Job For MSc Life Sciences
AIIMS New Delhi Project Associate Job For MSc Life Sciences
AIIMS New Delhi Project Associate Job For MSc Life Sciences. PA job opening at AIIMS....
WWF India Project Officer Species Vacancy For Life Sciences
WWF India Project Officer Species Vacancy For Life Sciences
WWF India Project Officer Species Vacancy For Life Sciences, Apply Online. MSc life sciences jobs. Project...
NIAB Senior Research Fellow Job Opening – Online Application Process
NIAB SRF Vacancy Available - Online Application Process
NIAB SRF Vacancy Available - Online Application Process. National Institute of Animal Biotechnology vacancy. MSc Natural Sciences...
IISER Berhampur JRF/Project Assistant Job Opening Available
IISER Berhampur JRF/Project Assistant Job Opening Available
IISER Berhampur JRF/Project Assistant Job Opening Available. IISER Berhampur is hiring Biological Science candidates for JRF/Project Assistant Job....
Bacardi Food Technology Liquid R&D Scientist Recruitment, Apply Online
Bacardi Food Technology Jobs - Liquid R&D Scientist, Apply Online
Bacardi Food Technology Jobs - Liquid R&D Scientist, Apply Online. Food Technology Jobs. Bacardi Jobs...
IISER Bhopal Summer Internship Program 2022, Apply Online
IISER Bhopal Summer Internship Program 2022, Apply Online
IISER Bhopal Summer Internship Program 2022, Apply Online. IISER Bhopal Summer Internship 2022. Interested and eligible applicants...
Bose Institute PhD Admissions 2022 For Spring Programme, Apply Online
Bose Institute Admissions 2022 PhD Spring Session, Apply Online
Bose Institute Admissions 2022 PhD Spring Session, Apply Online. PhD Spring Admissions 2022 at Bose Institute....